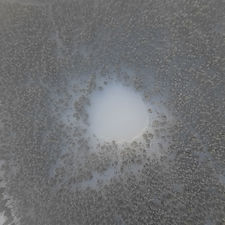
Carina-Heed.JPG

SVENSKA LANDSLAGET I FOTOGRAFI
TÄVLAR I WORLD PHOTOGRAPHIC CUP
(WPC)
Varje år representeras Sverige av ett landslag i den prestigefyllda internationella tävlingen World Photographic Cup (WPC). Är det din tur att bli uttagen till landslaget i år?
Landslaget tas ut bland svenska fotografer som utmärkt sig med starka tävlingsresultat framför allt i SM i Fotografi, men även genom framgångar i andra stora nationella och internationella tävlingar. Målet är alltid att sätta ihop ett så konkurrenskraftigt lag som möjligt för att maximera Sveriges chanser till goda resultat i WPC.
Urvalet av tävlande bilder utgår därför från WPC:s regler och kategoridefinitioner. Det innebär bland annat att:
• varje fotograf får delta med endast en bild per kategori
• bilder i WPC tävlar utan titlar (vilket innebär att bilder som är beroende av en stark titel kan fungera sämre i WPC)
• vissa regler kan skilja sig från SM's motsvarande kategorier (till exempel måste sportbilder vara tagna under ett faktiskt sportevenemang i WPC, medan arrangerade bilder är tillåtna i SM)
• antalet porträttkategorier i SM är många, medan i WPC finns endast 2 porträttkategorier vilket innebär att det är många porträttbilder som slåss om få platser i landslaget
Att vinna en medalj i SM är en stark merit, men innebär inte automatiskt en plats i landslaget. Medaljbilderna utgör dock en självklar grund i urvalsprocessen. I enstaka fall kan även bilder som inte placerat sig på medaljplats i SM bli aktuella, liksom bilder som deltagit i andra tävlingar än SM.
Uttagningen görs av en särskild WPC-kommitté som är särskilt tillsatt för uppdraget och som arbetar helt oberoende av SM-gruppen.
WPC TÄVLINGSKATEGORIER
Precis som för SM i Fotografi, så revideras kategorier och regler varje år utifrån vad behovet är. I World Photographic Cup är det 2026 tio tävlingskategorier:
-
Commercial
-
Illustration / Digital Art
-
Nature / Landscape
-
Nature / Wildlife
-
Illustrative Portrait
-
Natural Portrait
-
Reportage / Photojournalism
-
Sports
-
Wedding Documentery
-
Wedding Open
HÄR kan du läsa allt om WPC
JOHN HELLSTRÖM är kapten för svenska landslaget i fotografi. Arbetsuppgifterna består mestadels av kommunikation med WPC, SM i Fotografi och landslagsfotograferna.
Johns senaste SM meriter består av Guld, Silver och Brons i Bröllop – Porträtt 2022, Printdomare SM 2021, Silver i Natur – Landskap) 2021, Guld i Bröllop + Årets Bild 2020, samt topp-10 i WPC i klassen Wedding. Han är certifierad printmakare och hjälper andra fotografer med printar till SM. Han har doktorerat i Expert Performance i Idrott och är konsult till många elitidrottare, coacher och landslag inom golf.
Hellström Foto: www.hellstrom.com
Hellström Print: www.hellstromstudio.com
TEAM SWEDEN 2026
SVENSKA LANDSLAGET I FOTOGRAFI



ANNA ALMÉN
Commercial

THERESE ASPLUND
Commercial
Illustration/Digital Art
Natural Portrait

HANNA NERET
Commercial
Illustration/Digital Art
Illustrative portrait
Natural Portrait




RESULTAT 2026
BEST OF NATION, SWEDEN:
Hanna Neret, Illustrative Portrait
FINALISTER (TOPP 10):
Therese Asplund, Natural Portrait, 3rd place
Hanna Neret, Illustrative Portrait, 1st place
Therese Asplund, Illustration / Digital Art, 5th place
Hanna Neret, Illustration / Digital Art, 10th place
Fredrik Larsson, Reportage / Photojournalism, 4th place
Joel Marklund, Sports, 3rd place
John Hellström, Wedding Open, 3rd place
Karin Andersson, Wedding Reportage, 4th place
OVERALL TEAM SWEDEN 4TH PLACE
TEAM SWEDEN 2025
SVENSKA LANDSLAGET I FOTOGRAFI























RESULTAT 2025
BEST OF NATION, SWEDEN:
Hanna Neret, Illustration / Digital Art
FINALISTER (TOPP 10):
Martina Wärenfeldt, Natural Portrait, 6th place
Martina Wärenfeldt, Illustrative Portrait, 3rd place
Therese Asplund, Illustrative Portrait, 10th place
Hanna Neret, Illustration / Digital Art, 4th place
Elin Stahre, Illustratione / Digital Art, 9th place
Paul Hansen, Reportage / Photojournalism, 7th place
Joel Marklund, Sports, 3rd place
Jonathan Näckstrand, Sports, 3rd place
OVERALL TEAM SWEDEN 5TH PLACE
TEAM SWEDEN 2024
SVENSKA LANDSLAGET I FOTOGRAFI



ANDREAS HEMB
Nature Wildlife
ANNA ALMÉN
Commercial
Illustration / Digital Art

ANNETTE BJÖRKMAN
Wedding Open



CAROLIN LANDIN
Wedding Documentary
EIMI THORÉN
Nature Landscape

ELIN STAHRE
Natural Portrait



EVELYN WALLIN
Wedding Documentary
HANNA NERET
Illustration / Digital Art
Illustrative Portrait

HÉLENA PARMÉR
Natural Portrait



JENNY IVARSSON
Commercial
JOEL MARKLUND
Sports

JOHN HELLSTRÖM
Wedding Documentary
Wedding Open
Nature Wildlife



LINA KRONHOLM
Natural Portrait
MALIN SAYAVONG
Illustrative Portrait

MARTINA WÄRENFELDT
Illustrative Portrait




PETER KÅVELAND
Nature Landscape
PETTER ARVIDSON
Sports
SARA VICTORIA SANDBERG
Illustration / Digital Art
RESULTAT 2024
BEST OF NATION, SWEDEN:
Jonathan Näckstrand, Sports
FINALISTER (TOPP 10):
Elin Stahre, Natural Portrait, 5th place
Hanna Neret, Illustration / Digital Art, 5th place
Sara Sandberg, Illustration / Digital Art, 9th place
Susanne Nyström, Reportage / Documentary, 5th place
Jonathan Näckstrand, Sports, 1st place GOLD MEDAL
Petter Arvidson, Sports, 6th place
OVERALL TEAM SWEDEN 6TH PLACE
TEAM SWEDEN 2023
SVENSKA LANDSLAGET I FOTOGRAFI








ELINA LINDGREN
Commercial











ZANDRA ROSÉN
Reportage / Photojournalism
RESULTAT TIDIGARE ÅR
RESULTAT 2018
BEST OF NATION, SWEDEN:
Andreas Varro, Commercial
FINALISTER (TOPP 10):
Andreas Varro, Commercial, 3rd place
Andreas Varro, Illustration/Digital Art, 7th place
Laila Villebeck, Portrait, 6th place
Jenny Puronne, Portrait, 7th place
Ulrich Schulte, Reportage/Photojournalism, 5th place
OVERALL, TEAM SWEDEN 4TH PLACE



